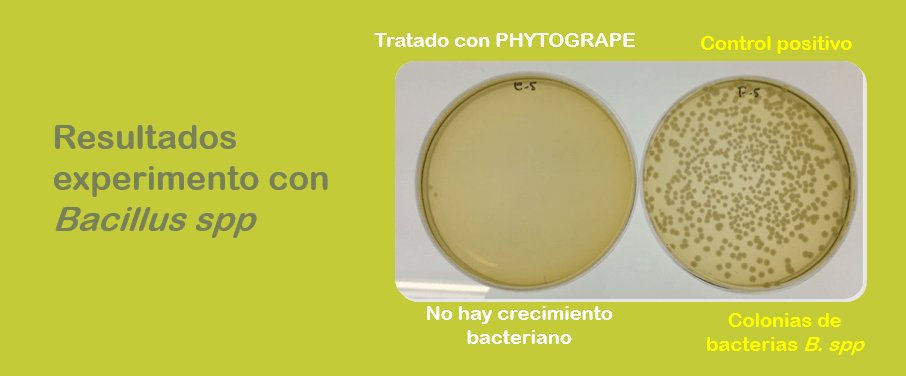
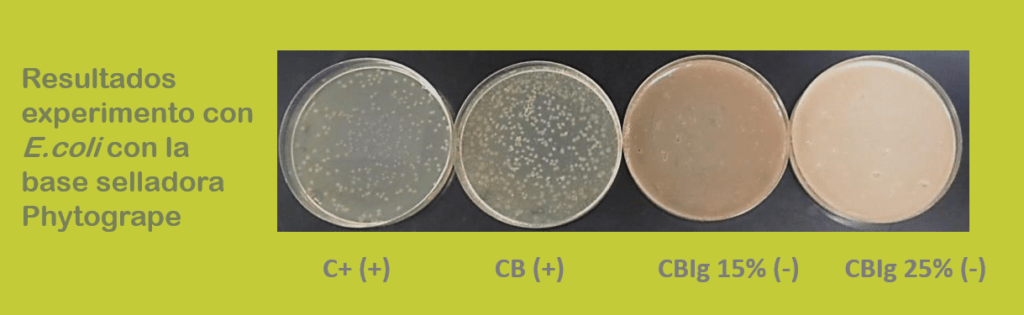

Pruebas bacteriológicas

Objetivos
Se pretende confirmar si la actividad antibacteriana de PhytoGrape es efectiva frente a Staphylococcus Aureus (Bacteria Gram +)
Material y métodos
-Medio de cultivo: Medio Luria Broth (LB) para bacterias: 1% triptona, 1% NaCl, 0,5% e:
-Condiciones de cultivo: las bacterias fueron cultivadas en medio LB a 37⁰C
-Soporte: placas Petri
Se pretende confirmar si la actividad antibacteriana de PhytoGrape es efectiva frente a Bacillus spp (Bacteria Gram +)
Objetivos
Se pretende confirmar si la actividad antibacteriana de PhytoGrape es efectiva frente a Escherichia Coli (Bacteria Gram -)
Material y métodos
-Medio de cultivo: Medio Luria Broth (LB) para bacterias: 1% triptona, 1% NaCl, 0,5% e:
-Condiciones de cultivo: las bacterias fueron cultivadas en medio LB a 37⁰C
-Soporte: placas Petri